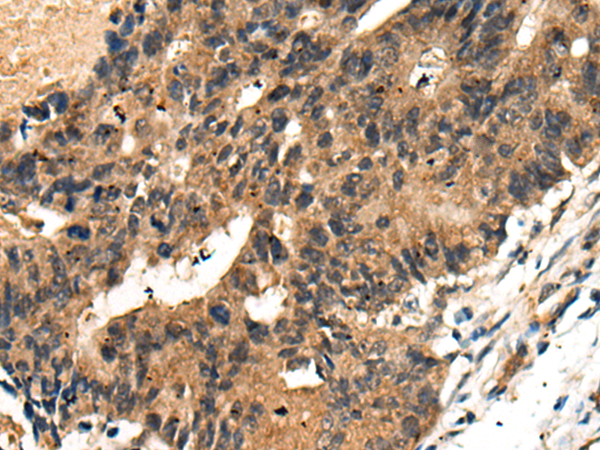

中文名稱:兔抗BMPER多克隆抗體
|
Background: |
This gene encodes a secreted protein that interacts with, and inhibits bone morphogenetic protein (BMP) function. It has been shown to inhibit BMP2- and BMP4-dependent osteoblast differentiation and BMP-dependent differentiation of the chondrogenic cells. Mutations in this gene are associated with a lethal skeletal disorder, diaphanospondylodysostosis. |
|
Applications: |
ELISA, IHC |
|
Name of antibody: |
BMPER |
|
Immunogen: |
Synthetic peptide of human BMPER |
|
Full name: |
BMP binding endothelial regulator |
|
Synonyms: |
CV2; CV-2; CRIM3 |
|
SwissProt: |
Q8N8U9 |
|
ELISA Recommended dilution: |
5000-10000 |
|
IHC positive control: |
Human liver cancer and human colorectal cancer |
|
IHC Recommend dilution: |
25-100 |

購物車
幫助
021-54845833/15800441009
